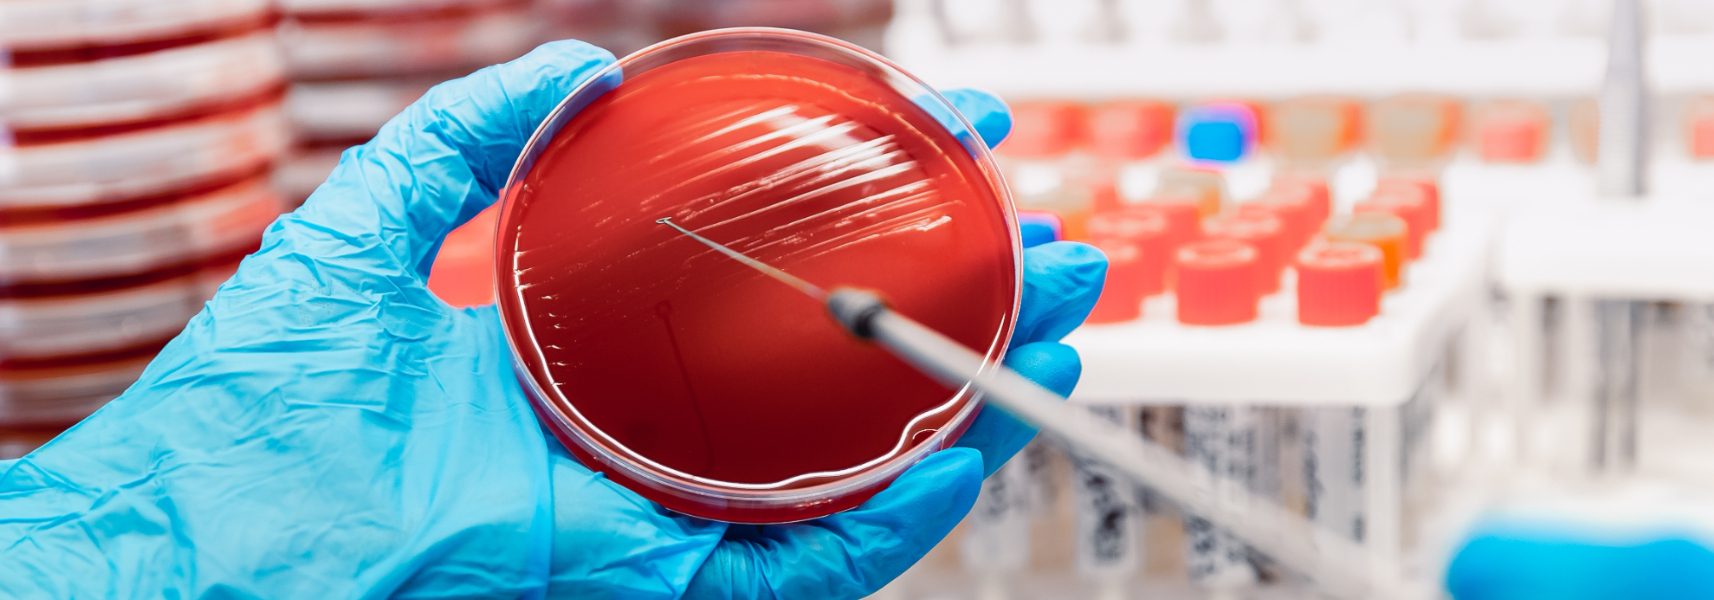

El análisis de superficies tiene como principal objetivo la verificación de los procesos de limpieza y desinfección aplicados en cada instalación, así como la determinación de si los productos utilizados y su dosis aplicada es la correcta.
Este tipo de analisis, abarca un amplio campo de aplicación ya que son susceptibles de control desde los utensilios utilizados en la fabricación de alimentos, bancadas de trabajo u otras zonas de contacto, cámaras de almacenamiento y manipuladores, suelos, bancadas, paredes, que tras su análisis nos dará información de las condiciones higiénico-sanitarias que presentan las zonas objeto de control.
Existen varios métodos en el mercado para realizar este tipo de control microbiológico, su elección vendrá condicionado por características de las superficies objeto y microorganismos buscados.
